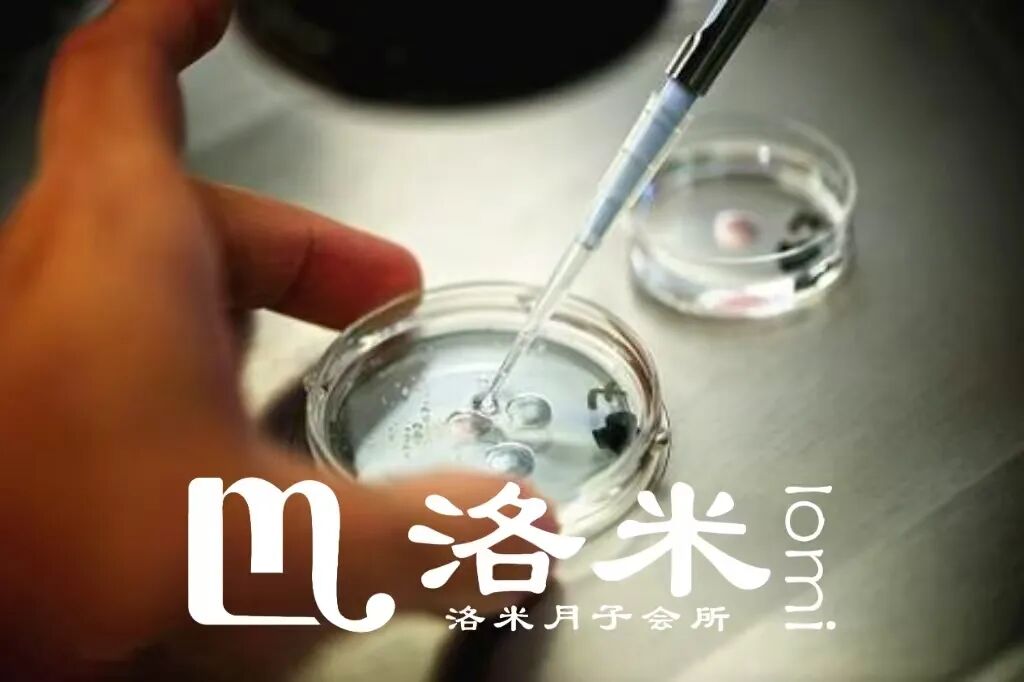

点击蓝字,关注我们

随着试管婴儿技术的普及,越来越多的家庭开始将目光投向海外,尤其是美国。当36岁的李女士第三次在国内试管失败后,她几乎要放弃希望。"医生说我卵巢功能衰退,胚胎质量总是不理想,每次移植都以失败告终。"直到她了解到美国试管婴儿的独特优势,才重新燃起了希望,这期洛米爸爸来和大家聊聊。
一、顶尖技术与个性化方案
李女士最终选择了洛杉矶的一家生殖中心。"他们并没有沿用国内的标准方案,而是专门为我制定了个体化治疗方案。"让李女士印象深刻的是,医生根据她每天的激素水平和卵泡发育情况,动态调整用药剂量。
"这种精细化的管理让我的取卵结果出乎意料——获得了9个成熟卵子,而此前在国内最多只取到过5个。"李女士的经历印证了美国生殖医学的核心理念:每个患者都需要量身定制的治疗方案。
美国的胚胎培养技术同样令人惊叹。"实验室采用时差显微镜系统,能够24小时不间断观察胚胎发育,无需将胚胎取出培养箱。"李女士的胚胎师解释说,"通过分析胚胎细胞分裂的时间和形态,我们可以选择最具发育潜能的胚胎。"
二、基因检测
对于李女士这样反复失败的患者,基因检测技术显得尤为重要。"我们培养出了6个囊胚,经过PGS筛查后发现,只有2个染色体完全正常。"这个结果让李女士既庆幸又后怕,"如果没做基因检测,我很可能会移植到那些看似优质实则异常的胚胎。"
加州的生殖专家莎拉医生指出:"对于35岁以上的女性,胚胎染色体异常率显著升高。通过PGS技术,我们可以识别染色体正常的胚胎,将着床率提高至70%以上,同时将流产率降低到5%以下。"
这项技术不仅提高了成功率,更确保了胎儿的健康。"得知移植的是染色体正常的胚胎,整个孕期我都安心很多。"李女士感慨道。

三、法律环境
美国完善的法律体系为各种辅助生殖需求提供了保障,这也是许多家庭选择赴美的重要原因。加州的生殖法律专家詹姆斯律师表示:"加州的助孕和卵子捐赠法律全美最为完善,对各方权利义务都有明确规定。"
虽然李女士不需要第三方辅助生殖,但她同样受益于美国完善的法律体系。"整个医疗过程都有详细的法律文书保障,用药、取卵、移植每个环节都规范透明,让人很放心。"
此外,美国的胚胎冷冻技术也受益于法律支持。"我们剩下的一个健康胚胎被玻璃化冷冻保存,诊所告知可以保存多年且复苏率很高,这为我们将来再要一个孩子提供了可能。"
四、成功率高
美国试管婴儿的成功率确实位居世界前列,这与其技术优势、严格监管和透明报告制度密不可分。
根据美国疾病控制与预防中心的数据,美国顶尖生殖中心35岁以下女性的试管婴儿活产率可达60%以上。李女士选择的生殖中心,在38-40岁年龄组的成功率也保持在45%左右。
"我们选择美国的一个重要原因是能够查阅到每个生殖中心的真实数据。"李女士说,"CDC官网可以查到各生殖中心不同年龄段的成功率,这些经过审核的数据让我们能做出更明智的选择。"
如今,抱着健康宝宝的李女士常常感慨:"虽然美国试管的费用更高,但考虑到成功率和安全保障,这笔投资是值得的。"不过她也提醒,每个家庭的情况不同,是否选择赴美试管,还需要综合考虑经济条件、时间成本和个人需求。

美国试管婴儿在技术精度、基因筛查、法律保障和成功率方面确实具有明显优势,但最重要的是选择最适合自己的方案。毕竟,在这条求子之路上,合适的才是最好的。
洛米赴美致力于为赴美孕妈提供高标准高品质全流程服务,提供详细的赴美资讯,我们欢迎您前来咨询!

往
期
回
顾

川普上任第一天,取消“双非出生”公民权!
2025赴美生子,六大好处和两大风险!
美宝选国籍+国籍证明,看这一篇就够了!
E
N
D

